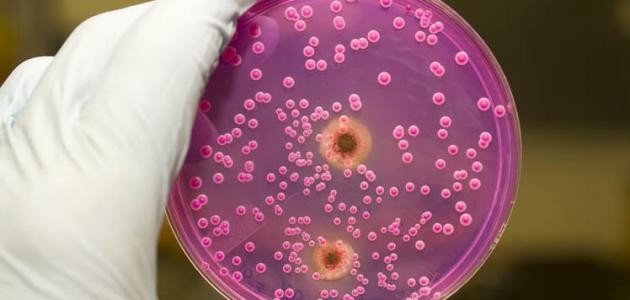
أنواع الفطريات وأهميتها

المحتويات
الفطريات
تعرف الفطريّات بأنّها كائنات حيّة حقيقيّة النواة غير متحرّكة، وغير ذاتيّة التغذية، وعادةً ما تكون وحيدة الخليّة، وتعيش هذه الكائنات في الهواء، والتربة، والمياه سواء كانت عذبة أو مالحة، كما يعيش بعضها متطفّلاً على الحيوانات أو النباتات، ممّا يسبب لها العديد من الأمراض، كما تعيش بعض الفطريّات في الظلام، حيث الدفء والرطوبة، وفي هذا المقال سنعرّفكم على أنواع الفطريّات.
أنواع الفطريات
الفطريات البيضية
تعيش الفطريّات البيضيّة مترمّمة على بقايا المواد العضويّة في الماء أو التربة، وقد يعيش بعضها متطفّلاً على النباتات، ممّا يسبّب لها العديد من الأمراض، ويتميّز هذا النوع من الفطريّات باحتواء جداره الخلوي على مادة السليولوز، بالإضافة لخلو غزلها الفطري من الجدر المستعرضة، كما أنّها تتكاثر بواسطة أعضاء التكاثر الجنسيّة الذكريّة التي تُنتج الأمشاج الذكريّة، المسؤولة عن تخصيب البويضات التي تنتجها أعضاء التكاثر الجنسيّة الأنثويّة، فيتكوّن الزايجوت الذي ينمو ويتطوّر ويصبح فطراً، ومن الأمثلة عليها فطريّات البياض الزغبي.
الفطريات الزيجوتية
تعيش الفطريّات الزيجوتيّة على بقايا المواد العضويّة في الماء أو في التربة، كما يعتمد قليل منها على التطفّل، وتتميّز هذه الفطريّات باحتواء جدارها الخلوي على الكيتين، وخلو غزلها الفطري من الجدر المستعرضة، وتتكاثر هذه الفطريّات لا جنسيّاً، عن طريق تكوين الجراثيم الكونيديّة، وجنسيّاً عن طريق تكوين الجراثيم الزيجوتيّة، التي تتميّز بقدرتها على مقاومة الظروف البيئيّة غير الملائمة؛ لوجود جدار سميك لها، ومن الأمثلة على الفطريّات الزيجوتيّة: فطر عفن الخبز، وفطريّات الجذور.
الفطريات الكيسية
تعيش هذه الفطريّات في مختلف البيئات؛ فهي تعيش معيشة رمّية، فيتطفّل بعضها إجباريّاً على أنسجة العائل، ويتطفّل بعضها الآخر اختياريّاً، ولا بد من الإشارة إلى أنّها تتكاثر جنسيّاً عن طريق تكوين الأبواغ الكيسيّة داخل الأكياس الزقّية، ولا جنسيّاً عن طريق تكوين الأبواغ الكونيديّة، ومن الأمثلة عليها: فطر البنسيليوم، وفطر الكمأة.
الفطريات البازيدية
تعيش هذه الفطريّات متطفّلة أو مترمّمة على التربة الغنيّة بالمواد العضويّة، أو على بقايا جذور الأشجار، وتعد هذه الفطريّات من أكثر أنواع الفطريّات تعقيداً وتضخّماً، ومن الأمثلة عليها: الفطريّات كبيرة الحجم، مثل فطر عش الغراب، والكرات النافخة، وفطر العرجون، والفطريّات المجهريّة مثل فطريّات الصدأ، والفطريّات البازيديّة تتكاثر لا جنسيّاً بتكوين الجراثيم الكلاميديّة، وجنسيّاً عن طريق تكوين تركيب خاص يعرف باسم الدعامة.
الفطريات الناقصة
تضم هذه المجموعة من الفطريّات حوالي 3000 نوع تقريباً، وتتميّز باحتوائها على غزل فطري مقسّم، وتتكاثر لا جنسيّاً عن طريق الأبواغ الكونيديّة، كما قد تتكاثر جنسيّاً، وتعيش هذه الفطريّات بطريقة رمّية في التربة أو فوق بقايا النباتات، ومن الأمثلة عليها: فطر الفيوزاريوم الذي يسبّب مرض الذبول، وفطر الألترناريا الذي يوجد في المناطق السوداء حول عنق الطماطم التالفة.
أهمية الفطريات
- تحلّل المواد العضويّة إلى مواد بسيطة.
- تستخدم غذاءً للإنسان، مثل: فطر الكمأة، وعيش الغراب.
- تدخل في صناعة بعض الأدوية، والخبز؛ لاحتوائها على فيتامين B.
- تستخدم في تطبيق الهندسة الوراثيّة.